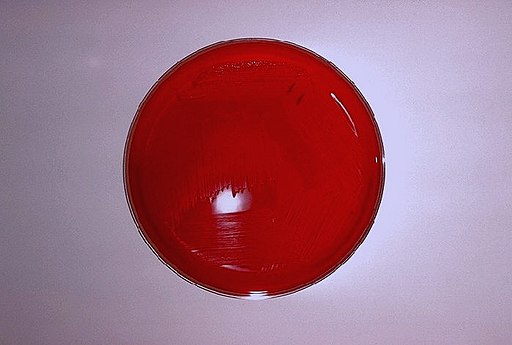

Brucella melitensis
Bakterie
Brucella melitensis je gram-negativní kokovitá bakterie z rodu Brucella. Jedná se o nepohyblivou, striktně aerobní, kataláza pozitivní bakterii, která se kultivuje na tryptonovém nebo Brucella agaru při atmosféře 10 % CO2. Je původcem brucelózy ovcí a koz. Nakazit se mohou velbloudi, skot, pes nebo člověk. Vyskytuje v celkem 3 různých biovarech, převažuje biovar 1. Wikipedia
Lidé také hledají
Brucella melitensis – Wikipedie
Brucella melitensis je gram-negativní kokovitá bakterie z rodu Brucella. Jedná se o nepohyblivou, striktně aerobní, kataláza pozitivní bakterii, která se kultivuje na tryptonovém nebo Brucella agaru při atmosféře 10 % CO 2.
Brucella melitensis - Wikipedia
Brucella melitensis is a Gram-negative coccobacillus bacterium from the Brucellaceae family. The bacterium causes ovine brucellosis, along with Brucella ovis.
Brucellosis - Wikipedia
Find sources: "Brucellosis" – news · newspapers · books · scholar · Jstor ( March 2025) (Learn how and when to remove this message)
Soubor:BrucellaMelitensis.jpg – Wikipedie
Tento obrázek je dílem zaměstnance Centers for Disease Control and Prevention, který je součástí United States Department of Health and Human Services, pořízeným nebo vytvořeným v rámci jeho pracovní náplně.
Brucelóza – Wikipedie
Člověk se může nakazit od infikovaných zvířat, nemoc se však mezi lidmi nepřenáší. [2 ] [3 ] Brucelóza u lidí je nejčastěji způsobena druhem B. melitensis, který je rozšířen v oblasti Středozemního moře, Blízkého a Středního východu…
Nový test na detekci bakterií Brucella melitensis v kozím mléce…
B. melitensis je jedním ze šesti druhů rodu Brucella, které vyvolávají potraty u zvířat, zejména u ovcí a koz. U lidí je infekce B. melitensis příčinou tvz. maltské horečky, která se projevuje zvýšenou teplotou a bolestmi hlavy.
Charakteristiky Brucella melitensis, morfologie, přenos…
Brucella melitensis je gramnegativní kokobacilární bakterie, která produkuje zoonotické onemocnění zvané brucelóza ovcí a koz. Infekce způsobuje značné ekonomické ztráty způsobením potratů ovcí a koz.
Brucelóza – WikiSkripta
Internetové studijní materiály pro studenty českých a slovenských lékařských fakult.
Více než 300 stock fotografií, snímků a obrázků bez autorských…
Vyhledávejte z Brucella Melitensis stock fotek, snímků a obrázků bez autorských poplatků od služby iStock. Vyhledejte zde vysoce kvalitní stock fotky, které jinde nenajdete.
Brucelóza - základní informace o onemocnění - SZÚ | Oficiální…
Rod Brucella obsahuje šest druhů, které se liší ve výběru rezervoárových zvířat, metabolických a kultivačních charakteristikách a v antigenní stavbě.
odkazuje na služby nejen od Seznam.cz.
© 1996–2025 Seznam.cz, a.s.